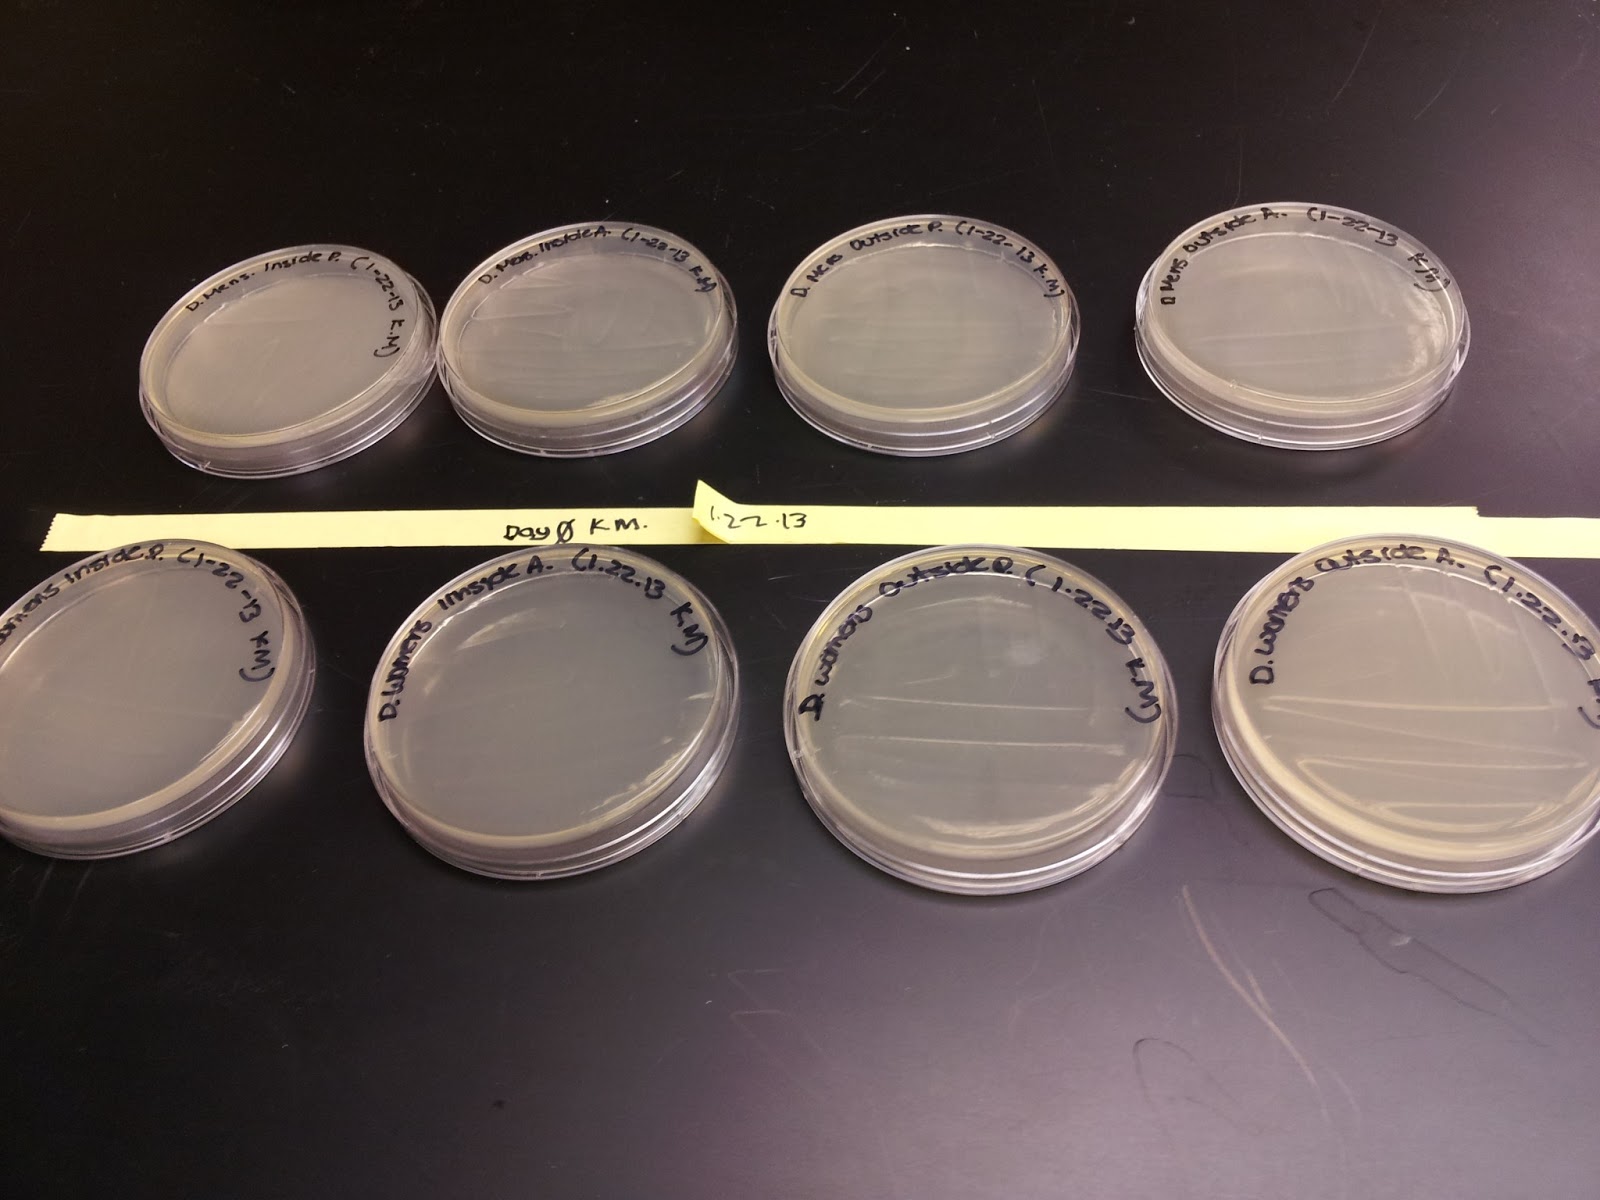

Hello fellow STEM students! I have been working on this list of REU's for a few days and this is what I came up with! REU stands for Research Experience for Undergrads. Most encourage juniors and seniors to apply but many also consider sophomores as great candidates as well! What's great about these is you get to travel to another city, do research and to meet new people from around the nation! Most of these are paid internships and include housing and so forth. I broke it down to majors and due dates for everyone to quickly find what they're looking for. I recommend choosing a few and applying to them. Most are due on the 15th of next month and you have to send out transcripts and have letters of recommendations done so get on it!!!!
If you're looking more specific to your area of study just Google and put (your major/area of study) REU and 2013 to find the ones being offered this summer!
Good luck to all, Khadidja Meghoufi
William & Mary Department of Physics- Williamsburg, VA
Physics students interested in research are encouraged to apply.
Due Date: February 1st, 2013.
University of California- Santa Cruz- Climate Change/Marine Ecosystems
I'm assuming any biology majors interested in climate change etc. can apply!
Due Date: February 15th, 2013
Miami University in Oxford, Ohio- Chemistry Majors.
This one seems most interesting to me!
Due Date; February 15th, 2013
Summer Research at Cornell University in Ithaca, New York
Minorities and females are encouraged to apply! Chemistry, Physics and Engineering majors are encouraged to apply!
Due Date: March 1st, 2013
Grand Valley State University- Allendale, Michigan- Math REU Program
For Mathematics majors!
Due Date: February 22, 2013
Illinois State University- Math REU
This one is for math majors who want to get into education specifically.
Due Date: March 15th, 2013
Nevis Physics Lab- Columbia University NYC
For Physics majors!
Due Date: February 22, 2013
Vanderbilt University- Nashville, Tennessee.
Science &Engineering majors encouraged to apply!
Due Date: February 15th, 2013
Oregon State University- Math REU
I heard the campus is beautiful! For mathematics majors :)
Due Date: February 20, 2013
University of Washington- Seattle
For physics majors.
Due Date: February 28, 2013
University of Kentucky- Engineering REU
Due Date: February 15, 2013
Purdue University- Indiana
Physics Majors apply!
Due Date: March 1, 2013
Georgia Tech- Atlanta
Chemistry & Biochemistry students!
Due Date: February 15, 2013
Texas A&M University
Chemistry Majors apply!
Due Date: February 15, 2013
University of Southern California- Los Angeles
Chemistry students encouraged to apply!
Due Date: February 15, 2013
Thursday, January 31, 2013
Thursday, January 24, 2013
Back To School!
Back to school, back to business! I was anticipating starting school again because I knew that my internship would start-up again also! It took a little while to get back into the lab, I had a little frozen moment when I had to plate my samples and I had to re-read the instructions on how to do so since I haven't done it in a while.
This week would be the first official week for experiment and Josh and I continue to learn more through our findings and plan on re-adjusting the procedures and so on to get the most accurate results and so forth. As I was taking samples of the doorknobs yesterday, I noticed an odd yellowish substance in the women's doorknobs. I got a tiny bit of it on the cotton swab and look forward to going back to the lab tomorrow to see what sort of bacteria is on it. Another thing I'm looking forward to is the research conference in March! it just happened to fall on my birthday and I think it's going to definitely be unforgettable!
This week has been so good to me! I'm getting settled down with my classes and professors. I'm more determined this semester than I've ever been. I'm looking forward to everything that this semester has in store for me. I hope you all had a good week. Check back next week to see what that yellow substance on the door could possibly be! Josh and I also are planning to start identifying the bacteria that we have so far so get excited for that as well! Thank you for reading!
Greetings, Khadidja M.
This week would be the first official week for experiment and Josh and I continue to learn more through our findings and plan on re-adjusting the procedures and so on to get the most accurate results and so forth. As I was taking samples of the doorknobs yesterday, I noticed an odd yellowish substance in the women's doorknobs. I got a tiny bit of it on the cotton swab and look forward to going back to the lab tomorrow to see what sort of bacteria is on it. Another thing I'm looking forward to is the research conference in March! it just happened to fall on my birthday and I think it's going to definitely be unforgettable!
![]() |
| Here is the photo of the yellowish substance on the door. I was really grossed out. Thank goodness for gloves! |
![]() |
| Ready for plating!!! |
![]() |
| Day Zero results came back clear, as expected. These are the disinfected samples so we are able to watch the growth increase day to day as the samples continue getting analyzed. |
![]() |
| Last but certainly not least, my favorite chocolate in the world. |
This week has been so good to me! I'm getting settled down with my classes and professors. I'm more determined this semester than I've ever been. I'm looking forward to everything that this semester has in store for me. I hope you all had a good week. Check back next week to see what that yellow substance on the door could possibly be! Josh and I also are planning to start identifying the bacteria that we have so far so get excited for that as well! Thank you for reading!
Greetings, Khadidja M.
Trial Week of Door-Knob Germ Experiment!
So, a few weeks ago, right before the winter break began, I started my door knob experiment. I always wondered which bathroom doorknob was germiest, the men's bathroom or the women's so this is the experiment I decided on conducting. Previous research has supported the idea that women are more likely to wash their hands after using the facilities and in a case-study conducted in Turkey found that women scored higher than men when it comes to proper hand-washing knowledge so this experiment is geared to further study those habits. I expect that overall data will show that less bacteria will grow in the women's doorknobs than on the men's doorknobs.
The first day, Josh showed me the different swabbing methods and we chose the isolation method to streak the swab samples onto the agar plates that I previously prepared. Afterwards, I went to collect the samples. It took some getting used to but now when I do my sampling, it feels some-what automatic.
At first, Josh and I decided to start with day zero, where we disinfect the surface that we take the samples from and the day zero are expected to come back clear. Day one and on-wards should have bacterial growth on the plates. The samples were checked every 48 hours and were initially stored in the incubator and later moved to the refrigerator to allow for bacterial growth to slow down. Bacterial colonies were put into the data sheet in my lab book.
I think that because of the winter flu season, the bacteria that was taken grew in large clusters and in different colors whereas the samples from this week (the second week of school ones) were smaller and more consistent throughout the plates.
This trial week has allowed me to get better at my sampling and plating technique as well. I also asked a lot of questions to make sure that I was doing everything to the best of my ability.
The first day, Josh showed me the different swabbing methods and we chose the isolation method to streak the swab samples onto the agar plates that I previously prepared. Afterwards, I went to collect the samples. It took some getting used to but now when I do my sampling, it feels some-what automatic.
At first, Josh and I decided to start with day zero, where we disinfect the surface that we take the samples from and the day zero are expected to come back clear. Day one and on-wards should have bacterial growth on the plates. The samples were checked every 48 hours and were initially stored in the incubator and later moved to the refrigerator to allow for bacterial growth to slow down. Bacterial colonies were put into the data sheet in my lab book.
![]() |
| Into the incubator we go! :) |
![]() |
| Ready to plate! |
![]() |
| This is the sample from the men's outside, posterior doorknob. |
![]() |
| bacteria. just fabulous! |
I think that because of the winter flu season, the bacteria that was taken grew in large clusters and in different colors whereas the samples from this week (the second week of school ones) were smaller and more consistent throughout the plates.
This trial week has allowed me to get better at my sampling and plating technique as well. I also asked a lot of questions to make sure that I was doing everything to the best of my ability.
P.S. I shall be posting my blog post for this week as well. You will be able to compare the results from this week with the trial week results from the winter break ones.
Thank you for reading :) Good luck to everyone this semester, whether you're taking classes, teaching or even both! Remember to treat yourself to something nice (i.e. a manicure, facial, massage or a trip to the park)!
Greetings, Khadidja M.
Subscribe to:
Comments (Atom)